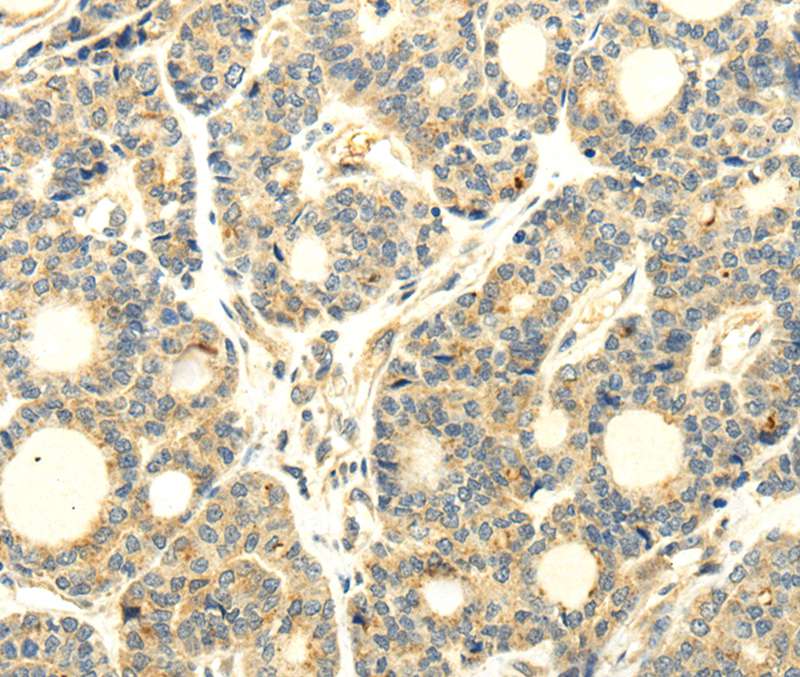

Immunohistochemistry of paraffin-embedded Human liver cancer tissue using TA371602 (WDR91 Antibody) at dilution 1/35 (Original magnification: ×200)
WDR91 Rabbit Polyclonal Antibody
TA371602
ApplicationsImmunoHistoChemistry
Product group Antibodies
ReactivityHuman, Mouse, Rat
TargetWDR91
Overview
- SupplierOriGene
- Product NameWDR91 Rabbit Polyclonal Antibody
- Delivery Days Customer14
- ApplicationsImmunoHistoChemistry
- CertificationResearch Use Only
- ClonalityPolyclonal
- Gene ID29062
- Target nameWDR91
- Target descriptionWD repeat domain 91
- Target synonymsHSPC049, SORF-1, SORF1, WD repeat-containing protein 91
- HostRabbit
- IsotypeIgG
- Protein IDA4D1P6
- Protein NameWD repeat-containing protein 91
- Scientific DescriptionWDR91 rabbit polyclonal antibody
- ReactivityHuman, Mouse, Rat
- Storage Instruction-20°C
- UNSPSC12352203